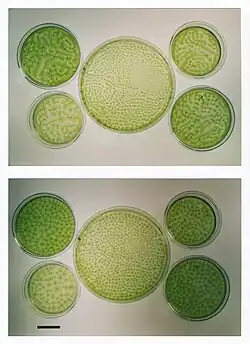

Biokonvektion

Biokonvektion ist eine Konvektionsströmung in dichten Kulturen frei schwimmender Mikroorganismen. Das Phänomen ist mindestens seit 1848 bekannt (Beschreibung durch Carl Wilhelm von Nägeli), wurde 1911 von Harold Wager näher untersucht[1] und erhielt 1961 von John R. Platt[2] seinen Namen. Angetrieben wird die Konvektionsströmung von einem Dichteunterschied in der Flüssigkeit, der durch das Aufwärtsschwimmen der Mikroorganismen entsteht.
Mechanismus
Die meisten frei schwimmenden Mikroorganismen haben eine etwas höhere Dichte als das sie umgebende Wasser oder Kulturmedium. Streben sie aufgrund einer Taxis (Orientierungsbewegung) der Oberfläche der Flüssigkeit zu, wird die obere Flüssigkeitsschicht schwerer als die darunter liegende Schicht. Sobald die Dichtedifferenz zwischen oberer und darunter liegender Flüssigkeitsschicht groß genug ist, wälzt sich die Flüssigkeit um. Dadurch werden die Organismen nach unten transportiert, von wo aus sie erneut nach oben schwimmen.
Wie etwa bei der Rayleigh-Bénard-Konvektion ist das so entstehende Muster anfangs unregelmäßig, da es vom Zufall abhängt, an welchen Stellen die kritische Dichtedifferenz zuerst erreicht wird. Durch die Wechselwirkung zwischen benachbarten Konvektionszellen wird es mit der Zeit regelmäßiger: ein Selbstorganisationsphänomen. Bei hinreichend hoher Kulturdichte (beispielsweise über 5·105 Algenzellen/Milliliter) und hinreichend flacher Flüssigkeitsschicht (etwa 2 bis 8 Millimeter) bilden sich periodische Muster heraus. Die Wellenlänge der Muster sinkt mit der Kulturkonzentration: Je mehr Organismen pro Volumeneinheit, desto größer der Dichteüberschuss der Oberflächenschicht und desto kleiner die Konvektionszellen. In Flüssigkeitsschichten mit einer Höhe von etwa 2 bis 8 Millimetern steigt die Wellenlänge mit der Schichtdicke der Flüssigkeitsschicht an.
In Flüssigkeitsschichten, die höher als etwa 8 Millimeter sind, stabilisiert sich das Muster nicht. Auch in hohen Flüssigkeitsschichten erkennt man aber von der Seite sogenannte plumes: Fahnen dichter, mit Mikroorganismen angereicherter Flüssigkeit, die von der Oberfläche nach unten sinken. Viele frei bewegliche Mikroorganismen schwimmen aufgrund der Drehmomente in einer Scherströmung in solche Fahnen hinein (sogenannte Gyrotaxis). Dadurch lösen sich die Fahnen nicht auf, sondern stabilisieren sich durch ihre ansteigende spezifische Dichte. Sie können bis zum Boden des Gefäßes reichen, von wo aus die Organismen wiederum nach oben schwimmen.
Muster
Die absinkenden, organismenreichen Flüssigkeitsregionen erscheinen von oben betrachtet als Punkte. Bei sehr hohen Organismenkonzentrationen verbinden sich diese Punkte zu Netzstrukturen, in denen nach einer Weile meist Drei- oder Vierecke vorherrschen. Neben Punkt- und Netzmustern können durch Reize, die die Schwimmaktivität oder die Vorzugsrichtung der Mikroorganismen beeinflussen, weitere Strukturen entstehen, etwa parallele Steifen, Sterne, gefüllte Polygone mit hellen Rändern (an das Fell einer Netzgiraffe erinnernd) oder in der Mitte hohle Flecken (an Leopardenfell erinnernd).
Mikroorganismen, bei denen Biokonvektion beobachtet wurde
Biokonvektionsmuster in dünnen Flüssigkulturschichten oder auch in natürlichen Pfützen und Lachen wurden bei einer Vielzahl frei schwimmender Mikroorganismen beobachtet:
- bei einzelligen Algen der Gattungen Chlamydomonas, Crypthecodinium, Dunaliella, Euglena, Glenodinium und Polytomella,
- bei koloniebildenden Algen wie Volvox,
- bei Dinoflagellaten wie Gonyaulax,
- bei Wimpertierchen (Ciliaten) wie Tetrahymena und
- bei Bakterien wie Bacillus subtilis, Chromatium okenii, Escherichia coli, Pseudomonas und Spirillum.
Gemeinsam ist ihnen, dass ihre spezifische Dichte etwas über der von Wasser liegt (etwa 3 bis 10 Prozent) und dass sie unter den Beobachtungsbedingungen aufgrund einer Taxis vorwiegend aufwärts schwimmen, sodass die Dichte der oberen Flüssigkeitsschicht steigt. Meist folgen sie einer negativen Gravitaxis, also einer dem Schwerkraftvektor entgegengerichteten Fortbewegung. Aber auch eine Aerotaxis, also eine Ausrichtung am Sauerstoffgradienten, kann zu einer Anreicherung der Organismen an der Oberfläche führen.
Literatur
- S. Ghorai, N. A. Hill: Wavelengths of Gyrotactic Plumes in Bioconvection. Bulletin of Mathematical Biology 62, 2000, S. 429–450, doi:10.1006/bulm.1999.0160 (PDF)
- A. Kamphuis: Biokonvektionsmuster in Kulturen der Alge Euglena gracilis. Mikrokosmos 85, 1996, S. 83–92 (Heft-PDF)
- C. R. Williams, M. A. Bees: A tale of three taxes: photo-gyro-gravitactic bioconvection. J Exp Biol 214, 2011, S. 2398–2408, doi:10.1242/jeb.051094 (Volltext)
Weblinks
N. Pfennig: Chromatium okenii (Thiorhodaceae) - Biokonvektion, aero- und phototaktisches Verhalten. Stummfilm, IWF Göttingen, 1965, doi:10.3203/IWF/E-1036; Biokonvektionsmuster: 1'56 bis 5'26.
Einzelnachweise
- ↑ H. Wager: On the Effect of Gravity upon the Movements and Aggregation of Euglena viridis, Ehrb., and Other Micro-Organisms. Philosophical Transactions B, Bd. 201, 1911, S. 274–281, doi:10.1098/rstb.1911.0007 (PDF)
- ↑ J. R. Platt: "Bioconvection Patterns" in Cultures of Free-Swimming Organisms. Science, Bd. 133, Nr. 3466, 1961, S. 1766–1767, doi:10.1126/science.133.3466.1766